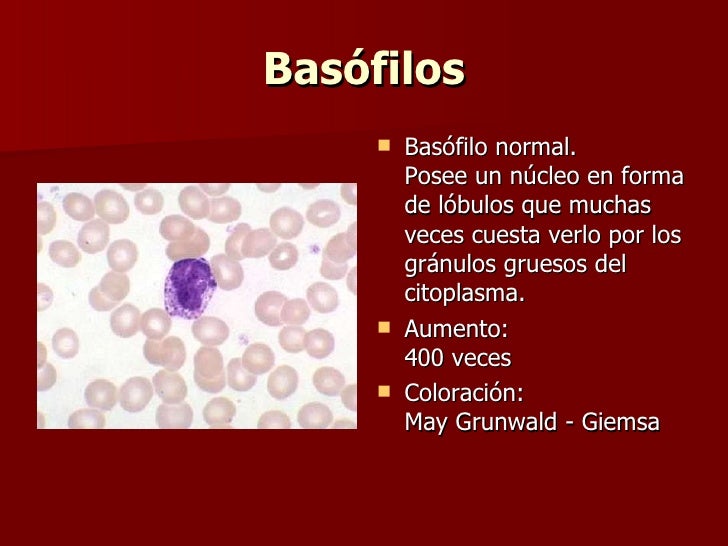

¿Cuáles son los valores normales de los basófilos?
Los basófilos están presentes en la sangre en concentraciones muy pequeñas, siendo los valores de referencia entre 0 y 2% ó 0 - 200/mm 3 tanto en los hombres como en las mujeres. Valores normales de los basófilos
¿Por qué aumentan los basófilos?
Es frecuente que los basófilos aumenten en casos de alergia, asma, rinitis o urticaria. La sangre está formada por glóbulos rojos, glóbulos blancos y plaquetas. Los leucocitos o glóbulos blancos son los encargados de defender al organismo de infecciones, siendo el principal componente de las repuestas inflamatorias e inmunitarias. Se dividen en:
¿Por qué los basófilos se sitúan por encima de lo normal?
Si en una analítica los marcadores indican que los basófilos se sitúan por encima de lo normal, lo habitual es que repita la toma de muestra sanguínea. Tener altos en sangre los basófilos también puede estar relacionado con: Infecciones víricas. Rinitis y sinusitis. Asma.
¿Por qué los basófilos son altos en sangre?
Tener altos en sangre los basófilos también puede estar relacionado con: Cuando se tienen los basófilos bajos se habla de basopenia. Es una situación rara que ocurre cuando disminuye la producción de glóbulos blancos en la médula ósea.

¿Cuántos basófilos es normal?
Linfocitos: 20% a 40% Monocitos: 2% a 8% Eosinófilos: 1% a 4% Basófilos: 0.5% a 1%
¿Qué significa tener los basófilos en 2?
Los niveles aumentados de basófilos en sangre pueden indicar: Leucemia mieloide crónica. Mielofibrosis primaria. Policitemia vera.
¿Qué son los basófilos en 0?
Son un tipo de célula inmunitaria, formada en la médula ósea, con pequeñas partículas que tienen enzimas que se liberan durante las reacciones alérgicas y el asma. Son los leucocitos menos numerosos, en torno a un 3%, y sus gránulos tienen histamina y heparina, sustancia que disuelve los coágulos.
¿Qué significa basófilos 05?
Basófilos bajos (basopenia) La basopenia es cuando los basófilos se encuentran en un porcentaje bajo, es una situación poco común y que normalmente ocurre debido a la disminución de la producción de los glóbulos blancos por la médula ósea, siendo posible identificar apenas 20 células por litro de sangre.
¿Que atacan los basófilos?
Por lo tanto, estas células ayudan al sistema inmunitario a través de la liberación de distintos componentes tales como citocinas, leucotrienos e histamina. En particular, los basófilos son realmente importantes en respuestas inmunitarias frente a parásitos, incluyendo garrapatas y filarias.
¿Que atacan los basófilos?
Por lo tanto, estas células ayudan al sistema inmunitario a través de la liberación de distintos componentes tales como citocinas, leucotrienos e histamina. En particular, los basófilos son realmente importantes en respuestas inmunitarias frente a parásitos, incluyendo garrapatas y filarias.
¿Qué hace el basófilo?
Tal y como se ha dicho, los basófilos son importantes para iniciar reacciones inflamatorias, pero su activación descontrolada también se ha vinculado a alergias, otras reacciones de hipersensibilidad, anafilaxias, asma y alteraciones dérmicas.
¿Cuál es el valor normal de basófilos?
Los basófilos están presentes en la sangre en concentraciones muy pequeñas, siendo los valores de referencia entre 0 y 2% ó 0 - 200/mm 3 tanto en los hombres como en las mujeres.
¿Qué son los basófilos y para qué sirven?
Los basófilos son células importantes para el sistema inmune, estando normalmente aumentados en casos de alergia o inflamación prolongada como asma, rinitis o urticaria por ejemplo. Los basófilos poseen en su estructura numerosos gránulos, que en situaciones de inflamación o alergia, por ejemplo, liberan heparina e histamina para combatir el problema.
¿Qué significa tener los basófilos altos?
El aumento de los basófilos en la sangre, conocido como basofilia, normalmente ocurre cuando hay alguna inflamación en el organismo, estando acompañada por otras alteraciones del leucograma. Algunas situaciones en las que puede haber aumento de los basófilos son:
¿Qué es la basopenia?
La basopenia es cuando los basófilos se encuentran en un porcentaje bajo, es una situación poco común y que normalmente ocurre debido a la disminución de la producción de los glóbulos blancos por la médula ósea, siendo posible identificar apenas 20 células por litro de sangre.
¿Qué es leucemia mieloide crónica?
Leucemia mieloide crónica, que es un tipo de cáncer en el que ocurre una alteración en la producción de células por la médula ósea debido a una mutación;
¿Dónde se encuentran los basófilos?
Los basófilos se forman en la médula ósea antes de pasar a la sangre. Una vez en el torrente sanguíneo los basófilos se trasladan a los tejidos (piel, mucosas) en respuesta a procesos inflamatorios o infecciosos.
¿Qué significa tener los basófilos altos?
Los valores de basófilos en la sangre por encima de lo normal pueden ser indicativos de padecer infecciones ( varicela, viruela etc.), inflamaciones ( colitis ulcerosa) o producirse por reacciones de hipersensibilidad a ciertos alimentos.
¿Qué es antiinfeccioso en medicina?
Antiinfeccioso: Actúan en las infecciones o las reacciones alérgicas liberando histamina, un vasodilatador que aumenta el flujo sanguíneo a los tejidos.
¿Cómo se pueden conocer los niveles de basófilos?
Los valores se pueden conocer a través de un hemograma o cultivo de sangre. El cual se recomienda hacer una vez al año y así poder localizar cualquier tipo de anomalía. Los basófilos son el tipo de glóbulo blanco, menos común en la sangre. Para realizar el examen de sangre que nos arroje los niveles o valores de la célula debemos acudir a una clínica médica, ahí pedir la prueba de reconocimiento de basófilos.
¿Qué son los basófilos?
Los basófilos forman parte del grupo de células blancas destinadas a combatir los problemas del sistema inmune, presentes en el sistema sanguíneo. Es decir, son parte de los leucocitos, conocidos como glóbulos blancos. Su forma es granulocita, eso se debe a que contiene gránulos en las membranas. Esos gránulos son los que ayudan al sistema inmune a batallar contra infecciones o inflamaciones.
¿Qué hace la heparina en el cuerpo humano?
Su trabajo es determinante en el sistema de defensas del cuerpo. Los valores de esta célula ayudan a evitar alergias y problemas respiratorios. Cuando se sienten en alerta, liberan histamina y heparina, estos son dilatadores de la sangre, impiden que se coagule de manera rápida, evitando así, desangramiento o retención de esta.
¿Qué pasa si tengo los glóbulos rojos altos?
El cuerpo quiere decirnos que sufre un virus o infecció n que está desequilibrando los valores. Un aumento hará que se destruyan los glóbulos rojos desgastados, por lo que el cambio de los números de estas células nos puede indicar enfermedades como las siguientes:
¿Dónde se encuentra la histamina?
Esta célula forma parte de 1% total de los leucocitos presente en la sangre, se genera en la médula ósea, contienen histamina que van desechando cuando el sistema inmune percibe diferentes infecciones y alergias.
¿Qué hacen los glóbulos blancos en el cuerpo humano?
Para evitar daños mayores, los glóbulos blancos hacen el trabajo de desgranulación en donde es requerido.
¿Qué es el Hipertioridismo?
Hipertioridismo: Los problemas con la tiroides se presentan con inflamaciones en la cara, aumento de peso y estreñimiento; esto puede ser por el aumento de la histamina en la sangre,
¿Qué son los basófilos y cuál es su función?
Su función es la de proteger al organismo frente al ataque de agentes externos como bacterias, virus o cualquier otro antígeno.
¿Qué pasa si tengo los basófilos altos?
Como hemos dicho anteriormente unos valores por encima de 200 ul, se les califica como basófilos altos, denominándose basofilia. Este desajuste provoca tanto infecciones respiratorias como trastornos en la sangre.
¿Qué es la basopenia?
Con el nombre de basopenia se denomina la situación de basófilos bajos en sangre, es decir un número inferior a 20 células por litro de sangre.
¿Dónde se encuentran las histaminas?
Se generan dentro de la médula ósea y es donde maduran, cuando son activadas, por la existencia de un agente externo liberan una sustancia química denominada histamina.
¿Qué son los basófilos?
Los basófilos son muy importantes para el sistema inmunológico. Son un tipo de célula inmunitaria, formada en la mé dula ósea, con pequeñas partículas que tienen enzimas que se liberan durante las reacciones alérgicas y el asma. Son los leucocitos menos numerosos, en torno a un 3%, y sus gránulos tienen histamina y heparina, sustancia que disuelve los coágulos. Cuando se liberan grandes cantidades en el choque anafiláctico, pueden ocasionar el fallecimiento de una persona.
¿Qué es la sangre y sus componentes?
La sangre está formada por glóbulos rojos, glóbulos blancos y plaquetas. Los leucocitos o glóbulos blancos son los encargados de defender al organismo de infecciones, siendo el principal componente de las repuestas inflamatorias e inmunitarias. Se dividen en:
¿Qué son los basófilos y cuál es su función?
Los basófilos son una especie de leucocitos, es decir de glóbulos blancos, pero bastante particulares, no sólo por el hecho de ser los menos abundantes y los más grandes dentro del flujo sanguíneo, sino porque también resultan importantes para regular múltiples funciones del sistema inmunológico , para defender al organismo de virus, bacterias y demás amenazas; aunque sus variaciones de nivel también pueden ser síntoma de algún tipo de enfermedad. Aquí conocerás más acerca de su funcionamiento, importancia y tratamientos.
¿Qué niveles de basófilos son irregulares?
Debido a que los basófilos pueden llegar a ser de niveles cercanos a cero (0,01 x 10^9 / litro) , es más difícil determinar la basopenia, como se denomina a este tipo de irregularidad, la cual normalmente también es un indicativo secundario de una enfermedad principal.
¿Cómo tratar la basopenia?
Alimentos ricos en vitamina D, como el pescado, las ostras, las setas o el huevo, podrían coadyuvar en el tratamiento para combatir la basopenia, así como también el consumo de frutas y verduras, ácido fólico o la vitamina A. En caso de ser fumador también se aconseja minimizar este problema, además de tomar en cuenta la importancia de no abusar de los antibióticos.
¿Dónde se encuentran los eosinófilos?
Al igual que los eosinófilos, tiene su origen en la médula ósea, siendo factores esenciales para regular la respuesta inflamatoria del organismo ante diversas infecciones parasitarias.
¿Qué indican los niveles bajos de basopenia?
El hecho de contar con menos de 20 células por cada microlitro de sangre, ya es un indicador de basopenia, es decir, un nivel por debajo de lo normal. Asimismo, clínicamente se considera que un adulto con niveles superiores a los 200/ μL o 640 μL en el caso de los recién nacidos, son ya una proporción muy por arriba de lo normal, y que por tanto pueden ser sinónimo de diversas infecciones, trastornos o enfermedades.
¿Qué es la basofilia y porque se produce?
Los basófilos se pueden llegar a multiplicar de forma desproporcionada, cuando no es suficiente la cantidad para combatir alguna toxina, o como síntoma de una enfermedad, a esta condición se le conoce como basofilia y aunque en ocasiones pudiera no presentar síntomas externos, puede llegar a volverse un indicador de afecciones graves.
¿Qué causa los basófilos altos?
Trastornos mieloproliferativos. Esta especie de afecciones donde se altera la producción de células en la médula ósea, también pueden ser la causa de basófilos altos, siendo la trombocitemia, la policitemia vera y la mielofibrosis los casos más comunes, aunque también puede llegar a ser un indicio de leucemia.
¿Qué son los basófilos?
Los basófilos son el tipo menos abundante de glóbulos blancos en la sangre. Igual que los neutrófilos, los monocitos, los linfocitos y los eosinófilos, los basófilos también juegan un papel fundamental para el sistema inmunitario del organismo luchando contra los agentes infecciosos que entran en el cuerpo. Además, estudiando este tipo de linfocito se puede determinar si tu cuerpo tiene una infección o una enfermedad que podría ser grave.
¿Qué pasa si tengo el bazo alto?
El aumento del bazo suele ser consecuencia de infecciones, anemia, cáncer y trastornos en la médula, así que podría ir relacionado con los basófilos altos.